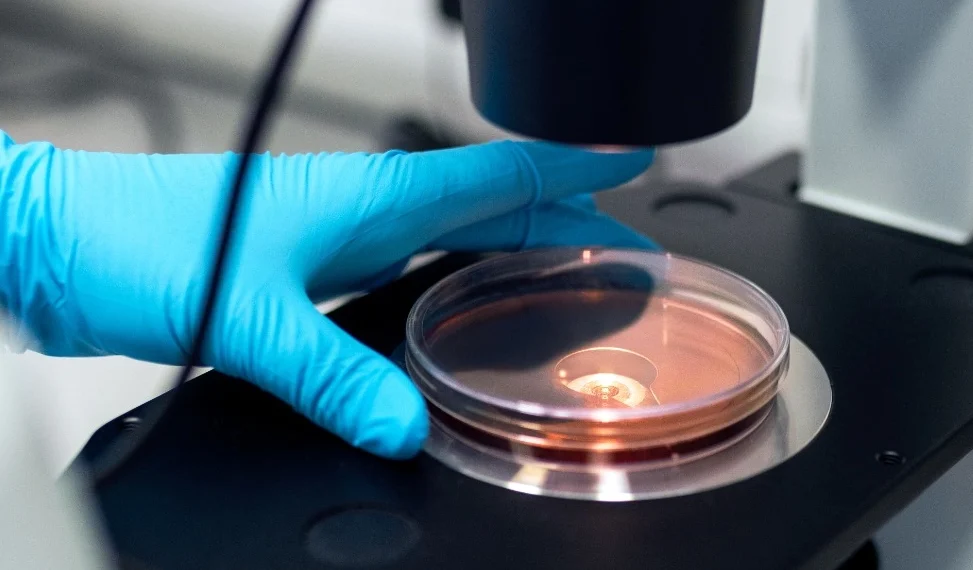

Tehokas palvelu sisäisen analytiikan laadun kehittämiseen
Nykyaikaiset elintarviketurvallisuusstandardit asettavat yhä enemmän vaatimuksia liittyen yritysten omien laboratorioiden ja tuotantoanalytiikan toiminnan luotettavuuteen. Käytännössä BRCGS Food, FSSC 22000 ja IFS Food odottavat ISO 17015 -standardin olennaisten vaatimusten noudattamista toiminnan kannalta merkitsevien analyysien suorittamisessa. Tässä on usein isojakin puutteita – lähtien vaikka sisäiseen analytiikkaan liittyvästä laatukäsikirjasta. Eli kuvauksesta siitä, mitä kaikkea teemme, jotta tuottamamme tulokset ovat oikein ja luotettavia.
Net-Foodlab Oy on tuottanut omissa laboratorioissaan analytiikkaa jo yli 25 vuoden ajan. Olemme olleet akkreditoitu* testauslaboratorio jo yli 20 vuoden ajan, joten meillä on poikkeuksellinen osaaminen tuotantolaitosten analytiikan ja niiden laboratorioiden laadunhallinnan kehittämiseen.
Tehokkaasti ja hyödyllisesti, turhaa työtä ja byrokratiaa välttäen. Me tunnemme sekä elintarviketuotannon että laboratorioiden vaatimukset.
*Net-Foodlab Oy:n Laboratorio on FINAS-akkreditointipalvelun akkreditoima testauslaboratorio T205, akkreditointivaatimus SFS-EN ISO/IEC17025. Tiedot akkreditoituun pätevyysalueeseen sisältyvästä toiminnasta ja toimipaikoista ovat nähtävissä verkkosivuilta www.finas.fi (Lue lisää täältä).